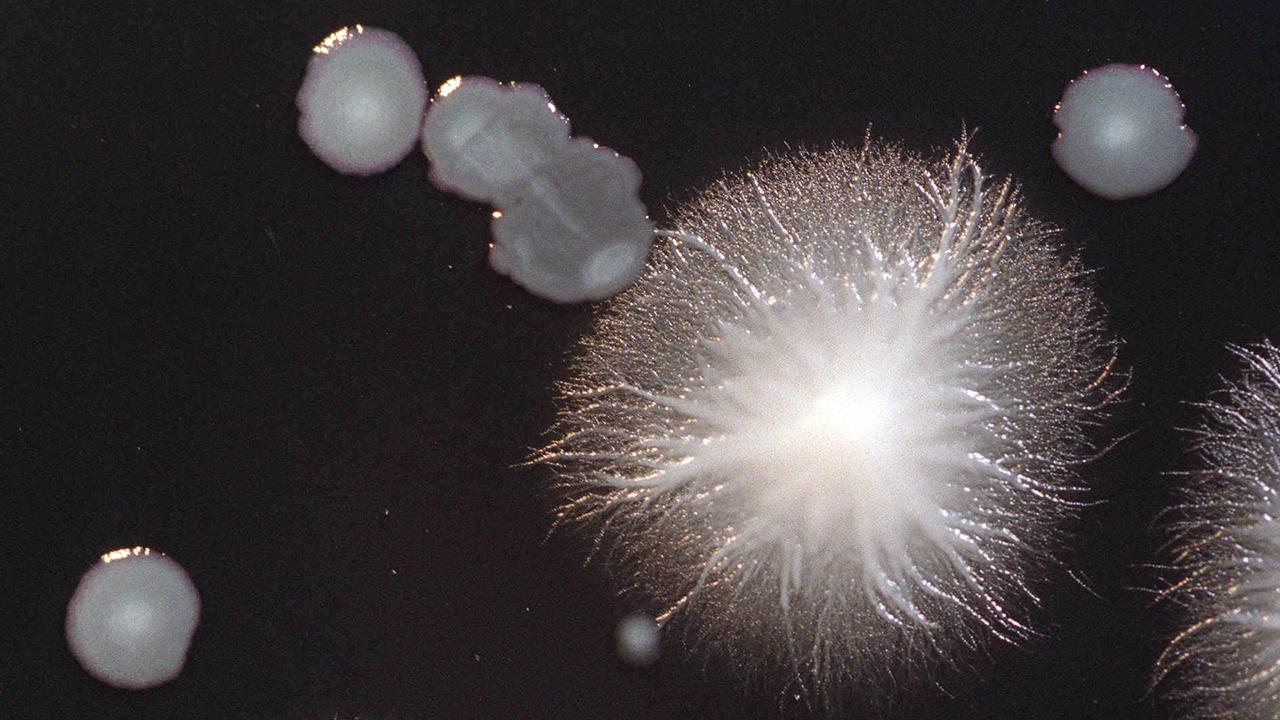

Mysterious Bacterial Outbreak Sparks Alert in Melbourne Suburb
A mysterious bacterial outbreak has raised concerns in a Melbourne suburb, prompting health authorities to take immediate action. The situation has led to multiple hospitalisations, with officials working urgently to trace the source of the infection.
The Department of Health is currently investigating an outbreak of Legionnaires’ disease in Craigieburn and nearby areas. As of March 18, there are six confirmed cases. All patients began experiencing symptoms in early March and required hospital treatment. This has triggered a swift public health response aimed at identifying where the infections originated.

Authorities believe that the exposure period could date back to late February. Investigations are now focusing on potential sources such as cooling towers and water systems in the area. These systems are known to be common breeding grounds for the bacteria that cause Legionnaires’ disease.
Residents and visitors to Craigieburn, Mickleham, Greenvale, and Roxburgh Park have been advised to seek urgent medical attention if they develop flu-like symptoms. These symptoms include fever, chills, muscle aches, and a persistent cough. Early detection and treatment are crucial to preventing severe complications.
Legionnaires’ disease is caused by Legionella bacteria, which can be found in both natural water sources like rivers and lakes, as well as in artificial systems such as spas and large-scale cooling units. The illness spreads when people inhale contaminated water droplets, but it cannot be passed from one person to another.
While many individuals exposed to the bacteria do not become ill, certain groups are more vulnerable. These include older adults, smokers, and people with weakened immune systems or underlying health conditions. Health professionals have been placed on high alert and are urged to consider Legionnaires’ disease in patients presenting with severe or unusual pneumonia, especially if they have recently visited the affected areas.
Early diagnosis is essential in managing the disease. Authorities emphasize the importance of rapid testing and antibiotic treatment to prevent serious complications. These can include pneumonia and, in some cases, kidney impairment.
The Department of Health has also reminded clinicians that any suspected cases must be reported immediately. This is part of ongoing efforts to contain the outbreak and identify its source. Public health officials are working closely with local communities to ensure that everyone is informed and aware of the risks.
As the investigation continues, residents are encouraged to remain vigilant and report any symptoms they may experience. The health department is also conducting further checks on water systems and other potential sources of contamination to prevent further spread of the disease.
This outbreak serves as a reminder of the importance of maintaining clean and safe water systems, particularly in urban areas where large-scale cooling units and other artificial water sources are common. It also highlights the need for continued public awareness and education about Legionnaires’ disease and how it can be prevented.
Health authorities are committed to keeping the community informed throughout the investigation. Updates will be provided as new information becomes available. In the meantime, residents are advised to follow the guidelines issued by the Department of Health and seek medical attention promptly if they experience any symptoms.





















